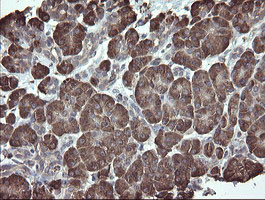
PDIA3 Antibody in Immunohistochemistry (Paraffin) (IHC (P))

Search
OriGene
PDIA3 Monoclonal Antibody (OTI3E1), TrueMAB™
{{$productOrderCtrl.translations['antibody.pdp.commerceCard.promotion.promotions']}}
{{$productOrderCtrl.translations['antibody.pdp.commerceCard.promotion.viewpromo']}}
{{$productOrderCtrl.translations['antibody.pdp.commerceCard.promotion.promocode']}}: {{promo.promoCode}} {{promo.promoTitle}} {{promo.promoDescription}}. {{$productOrderCtrl.translations['antibody.pdp.commerceCard.promotion.learnmore']}}
产品信息
CF504995
种属反应
宿主/亚型
分类
类型
克隆号
抗原
偶联物
形式
浓度
纯化类型
保存液
内含物
保存条件
运输条件
产品详细信息
For reconstitution, we recommend adding 100 µL distilled water to a final antibody concentration of about 1 mg/mL. To use this carrier-free antibody for conjugation experiments, we strongly recommend performing another round of desalting. (Zeba Spin Desalting Columns, 7KMWCO, 0.5 mL, Product # 89882)
靶标信息
This gene encodes a protein of the endoplasmic reticulum that interacts with lectin chaperones calreticulin and calnexin to modulate folding of newly synthesized glycoproteins. The protein was once thought to be a phospholipase; however, it has been demonstrated that the protein actually has protein disulfide isomerase activity. It is thought that complexes of lectins and this protein mediate protein folding by promoting formation of disulfide bonds in their glycoprotein substrates.
仅用于科研。不用于诊断过程。未经明确授权不得转售。
篇参考文献 (0)
生物信息学
蛋白别名: 58 kDa glucose-regulated protein; 58 kDa microsomal protein; Disulfide isomerase ER-60; endoplasmic reticulum P58; Endoplasmic reticulum resident protein 57; Endoplasmic reticulum resident protein 60; epididymis secretory protein Li 269; epididymis secretory sperm binding protein Li 93n; ER p57; ER protein 57; ER protein 60; ERp 57; glucose regulated protein, 58kDa; GRP 57; GRP 58; p58; PDIA 3; phospholipase C-alpha; PI PLC; protein disulfide isomerase family A, member 3; protein disulfide isomerase-associated 3; Protein disulfide-isomerase A3
基因别名: ER60; ERP57; ERP60; ERp61; GRP57; GRP58; HEL-S-269; HEL-S-93n; HsT17083; P58; PDIA3; PI-PLC
UniProt ID: (Human) P30101
Entrez Gene ID: (Human) 2923